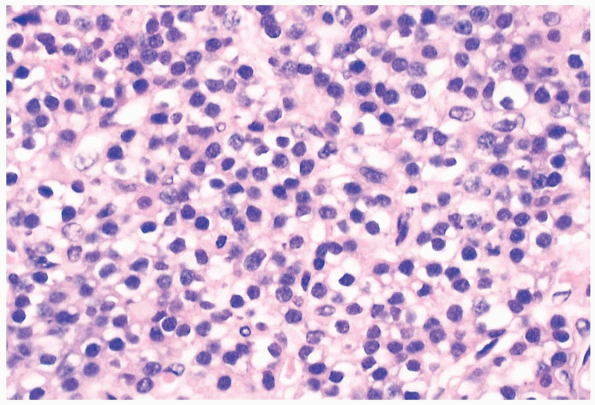

1
Q

A
Ultimobranchial body rest in thryoid
- Gives rise to C cells
2
Q

A
Lingual thyroid
- dense fibrous tissue
3
Q

A
Parathyroid tissue in thyroid capsule
4
Q

A
Normal thryoid
- cuboidal epihtelial cells with reich vacular network
5
Q

A
Palpation thyroiditis
- histiocytes and lymphocytes
6
Q

A
Hashimoto’s thyroiditis
7
Q

A
Radiation change, nodular goiter
8
Q

A
Hemochromatosis, PPB
9
Q

A
Papillary thyroid carcinoma
10
Q

A
Metastatic PTC in LN
- +: CK, thyroglobulin
11
Q

A
PTC, solid variant
12
Q

A
Follicular adenoma
- no capsular or vascular invasion
- microfollicular pattern, thinly encapsulated
13
Q

A
Follicular carcinoma
- BM bx showing thyroid follicles
- capsular invasion by primary
- vascular invasion in primary specimen
14
Q

A
Hurthle cell nodule with extensive necrosis
15
Q

A
Medullary carcinoma
- nests of rounded mildly pleomorphic cells surrounded by amyloid
16
Q

A
Medullary carcinoma
- +: calcitonin, CEA
17
Q

A
C cell nodular proliferation
- MEN2A
- +: calcitonin
18
Q

A
Insular carcinoma
- poorly differentiated
- showing some neuroendocrine growth pattern
19
Q

A
DLBCL in pt with Hashimoto’s thyroiditis
20
Q

A
Post-FNA infarction of thyroid
21
Q

A
Normal parathyroid
22
Q
A
Parathyroid adenoma
- lack of fat
23
Q

A
Parathryoid carcinoma
- invasion of other structures
- vascular invasion
- mitoses
- nuclear pleomorphism present
- intranuclear pseudoinclusions
24
Q

A
Parathyroid carcinoma
- Difficult to make dx on histo but mitoses helpful
- Gross and clinical showing invasion of other structures best indicator
25

Normal parathyroid, Oil Red O
* 80% are nonsecretory phase and contain intracytoplasmic fat
26

Parathyroid adenoma, Oil Red O
* total absence of fat


